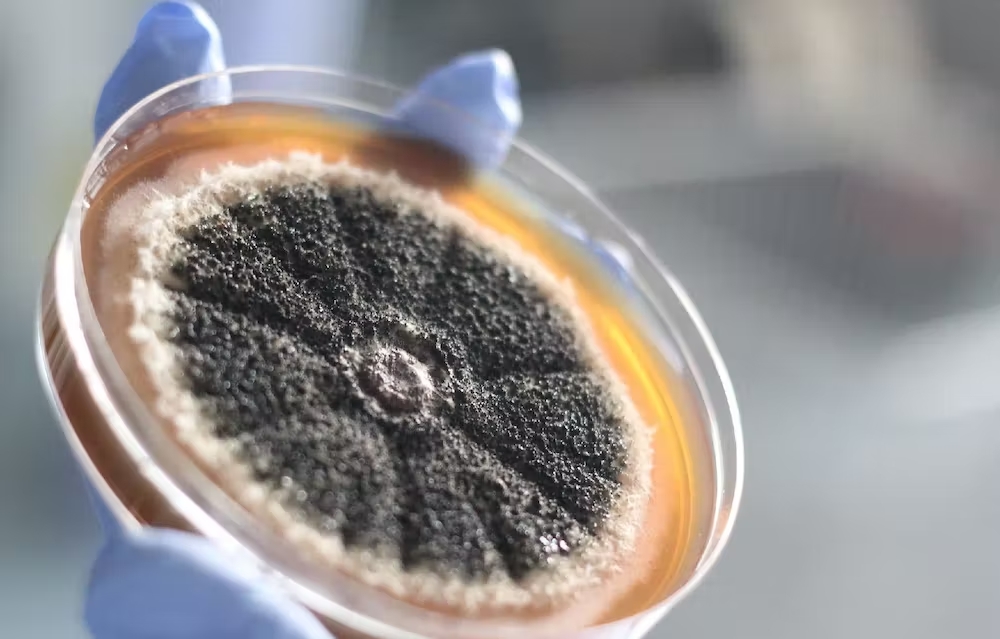

کسی بھی دوا کے دنیا کی تاریخ پر مرتب کردہ اثرات کا جائزہ پیش کرنا مشکل کام ہے، لیکن یہاں ہم پانچ ایسی ادویات کا ذکر کرنے جا رہے ہیں جن کے بارے میں آسانی سے دعویٰ کیا جا سکتا ہے کہ انہوں نے ہماری زندگیوں کو بہت بڑے پیمانے پر تبدیل کیا اور اکثر ایسے طریقوں سے جو ہمارے وہم و گمان میں بھی نہ تھے۔
یہ ادویات اپنے ساتھ کچھ ناقابل یقین فوائد لائیں۔ لیکن بالعموم ان کی میراث میں فوائد کے ساتھ ساتھ کئی طرح کی پیچیدگیاں بھی شامل ہیں جن کو ہمیں تنقیدی نگاہ سے دیکھنے کی ضرورت ہے۔
یہ بات اچھی طرح یاد رہنی چاہیے کہ آج جو دوا ہمیں اپنے فوائد سے حیرت میں مبتلا کر رہی ہے وہی کل کو پریشانیوں کا باعث بھی بن سکتی ہے۔
1: بےہوشی کی دوا
اٹھارویں صدی کے اواخر میں ایک انگریز کیمیا دان جوزف پریسلی نے ایک گیس بنائی جسے اس نے ’فلوجسٹکیٹڈ نائٹرس ایئر‘ (نائٹرس آکسائیڈ) کا نام دیا۔
انگریز کیما دان ہمفری ڈیوی کا خیال تھا کہ اسے سرجری میں درد سے نجات کے طور پر استعمال کیا جا سکتا ہے اگرچہ اس کے بجائے بہت جلد یہ ایک تفریحی نشہ بن گئی۔
اس سلسلے میں اگلی بڑی پیش رفت 1834 میں ہوئی جب فرانسیسی کیمیا دان ژاں بیپٹیس دوماس نے ایک نئی گیس کلوروفارم تیار کر لی۔
سکاٹش ڈاکٹر جیمز ینگ سمپسن نے 1847 میں اسے بچے کی پیدائش کے عمل کو آسان بنانے کے لیے استعمال کیا۔
جلد ہی بےہوشی کی دوا کو سرجری کے دوران زیادہ وسیع پیمانے پر استعمال کیا جانے لگا اور اس کے نتائج کافی حوصلہ افزا تھے۔
اینستھیزیا سے پہلے جراحی کا عمل انتہائی تکلیف دہ اور ناقابل برداشت تھا۔ تصور کیجیے کہ ایک جیتے جاگتے شخص کے جسم کی تیز دھار آلات سے چیر پھاڑ کی جا رہی ہے اور پھر سوئی کی نوک سے ٹانکے لگائے جا رہے ہیں۔ یہاں تک کہ مریض اکثر درد کی شدت سے مر جایا کرتے تھے۔
لیکن کوئی بھی دوا جو لوگوں کو بے ہوش کر سکتی ہے وہ نقصان کا باعث بھی بن سکتی ہے۔ آج بھی بےہوشی کے لیے استعمال ہونے والی ادویات خطرے سے خالی تصور نہیں کی جاتیں کیونکہ یہ اعصابی نظام کی بتی ہمیشہ کے لیے گل کر سکتی ہیں۔
2: پینسلین
1928 میں سکاٹ لینڈ کے ڈاکٹر الیگزینڈر فلیمنگ کے ساتھ جو کچھ ہوا وہ حادثاتی طور پر دریافت ہونے والی ادویات کے کلاسیکی واقعات کی ایک بہترین مثال ہے۔
فلیمنگ اپنی لیبارٹری کی میز پر سٹریپٹوکوکس نامی بیکٹیریا کی کچھ نمونوں کو چھوڑ کر چھٹی پر چلے گئے۔
جب واپس آئے تو انہوں نے دیکھا کہ ہوا میں موجود پینیسلیم نامی ایک قسم کی پھپھوندی نے اس بیکٹریا کو بڑھنے سے روک دیا ہے۔
انہوں نے اس پھپھوندی سے جو مادہ الگ کیا اسے پینسلین کا نام دیا گیا۔ آسٹریلوی پیتھالوجسٹ ہاورڈ فلوری اور ان کی ٹیم نے پینسلین کو مستحکم کیا اور پہلا انسانی تجربہ کیا۔
امریکہ کی مالی اعانت سے پینسلین کو بڑے پیمانے پر تیار کیا گیا اور دوسری جنگ عظیم کا رخ بدل دیا۔ اس کا استعمال ہزاروں فوجیوں کے علاج کے لیے کیا گیا تھا۔
پینسلین اور اس کی نسل کی ادویات ایک ہی حملے میں لاکھوں لوگوں کی ہلاکت کا باعث بننے والی بیماریوں کے خلاف انتہائی بنیادی کردار ادا کرتی ہیں۔
تاہم ان کے وسیع پیمانے پر استعمال سے کچھ بیکٹیریا دیگر امراض کے علاج میں استعمال ہونے والی ادویات کو موثر نہیں ہونے دیتے۔
فلیمنگ کی انسانیت سے گہری محبت کا اس سے بڑھ کر اظہار کیا ہو سکتا ہے کہ انہوں نے پینسلین کے حقوق اپنے پاس رکھ کر یا اسے فروخت کر کے مال بنانے سے گریز کیا۔
طبی شعبے میں اکثر جب وسیع تر انسانی اخلاقیات کا ذکر ہوتا ہے ان کا یہ قول بقول مثال پیش کیا جاتا ہے کہ ’میں نے پنسلین دریافت کی اور انسانیت کی بھلائی کے لیے مفت میں دے دی۔
بھلا کس لیے اسے دوسرے ملکوں میں صنعت کاروں کی منافع بخش اجارہ داری کی نذر کر دیا جاتا؟‘
3: نائٹروگلسرین
نائٹروگلسرین کی ایجاد 1847 میں ہوئی تھی اور اس نے دنیا کے سب سے طاقتور دھماکہ خیز مواد کے طور پر بارود کو پیچھے چھوڑ دیا تھا۔
لیکن بعد میں پتہ چلا کہ یہ تباہ کن مواد یہ سینے میں درد کا باعث بننے والی دل کے امراض سے منسلک بیماری انجائنا کا علاج کرنے والی پہلی جدید دوا کے طور پر بھی استعمال ہو سکتی ہے۔
اس بات کا علم یوں ہوا کہ دھماکہ خیز مواد کا براہ راست سامنا کرنے والے فیکٹری کارکنان کے سر میں درد اور چہرے پر جھریاں پڑنے لگیں۔
جب سائنس دانوں نے تحقیق کی تو معلوم ہوا کہ اس کی وجہ یہ ہے کہ نائٹروگلسرین ایک ویزوڈائلیٹر ہے یعنی یہ خون کی نالیوں کو پھیلاتا یا کھلا کر دیتی ہے۔
لندن کے معالج ولیم موریل نے اپنے اوپر نائٹروگلسرین کا تجربہ کیا اور اسے انجائنا کے مریضوں پر آزمایا، جس سے انہیں تقریباً فوری آرام مل گیا۔
نائٹروگلسرین نے انجائنا میں مبتلا لاکھوں لوگوں کے لیے نسبتاً معمول کی زندگی گزارنا ممکن بنایا۔
اس نے بلڈ پریشر کو کم کرنے والی، دل کی دھڑکن کو معمول پر لانے والی اور خون میں کولیسٹرول کی مقدار گھٹانے والی ادویات سمیت ایسی کئی دیگر دوائیوں کی بھی راہ ہموار کی۔ ان ادویات نے مغربی ممالک میں زندگی کو بڑھایا اور اوسط عمر میں اضافہ کیا ہے۔
لیکن چونکہ لوگوں کی زندگیاں طویل ہو گئی ہیں اس لیے اب کینسر اور دیگر غیر متعدی بیماریوں سے اموات کی شرح زیادہ ہو گئی ہے۔ کیونکہ بڑھتی عمر کے ساتھ بہت سے انسانی خلیے غیر فعال ہو کر زہریلے مادوں کی شکل اختیار کر لیتے ہیں اور بالآخر موزی امراض ہمیں موت کی طرف تیزی سے دھکیلنے لگتی ہیں۔ بہرحال ہم کہہ سکتے ہیں کہ نائٹروگلسرین نے دنیا کو ایسے بدلا جیسے کوئی سوچ بھی نہیں سکتا تھا۔
4: مانع حمل گولی
1920 کی دہائی کے اوائل میں آسٹریا کے سائنس دان لوڈوگ ہیبرلینڈ نے ایک تحقیقی مقالے میں بتایا کہ کس طرح جانوروں میں ہارمونز کے اتار چڑھاؤ سے حمل کو روکا جا سکتا ہے۔
انہیں اپنے ساتھیوں کی شدید تنقید کا سامنا کرنا پڑا لیکن اس کے باوجود انہوں نے مادہ خرگوش پر اپنے تجربات کیے۔ 1932 میں ان کی مبینہ خودکشی سے یہ باب وہیں بند ہو گیا۔ چند دہائیوں بعد امریکہ میں ایسے تجربات زیادہ مؤثر طریقے سے کیے گئے۔
شرح پیدائش کم کرنے کے زبردست حامی اور امریکہ سے تعلق رکھنے والی مصنفہ مارگریٹ سینگر نے محقق گریگری پنکس سے ایسی دوا تیار کرنے کے لیے کہا جو ہارمونل مانع حمل ہو۔
اس کے لیے مالی اعانت کیتھرین میک کورمک نے پیش کی تھی جنہیں وراثت میں کثیر سرمایہ منتقل ہوا تھا۔
اپنی تحقیق کے نتیجے میں پنکس کو معلوم ہوا کہ پروجیسٹرون بیضہ دانی میں سے انڈے کے اخراج کو روکتا ہے جسے انہوں نے آزمائشی گولی تیار کرنے کے لیے استعمال کیا۔
کلینیکل ٹرائلز خاص طور پر پورٹو ریکو میں کمزور طبقے سے تعلق رکھنے والی خواتین پر کیے گئے جس پر تشویش کا اظہار کیا گیا کہ انہیں پہلے سے اس کے فوائد، خطرات اور ضمنی مضر اثرات سے آگاہ نہیں کیا گیا تھا۔
مزید پڑھ
اس سیکشن میں متعلقہ حوالہ پوائنٹس شامل ہیں (Related Nodes field)
نئی دوا امریکہ کی فوڈ اینڈ ڈرگ انتظامیہ کی منظوری کے بعد جی ڈی سرل اینڈ کمپنی کی طرف سے 1960 میں اینوئڈ کے نام کے ساتھ مارکیٹ میں پیش کی گئی۔
اس کی اجازت اس لیے دی گئی کہ حمل کے نتیجے میں پیدا ہونے والے خطرات کے مقابلے میں اس کے خون کو گاڑھا کرنے اور فالج جیسے ضمنی خطرات کئی درجے کم مہلک تھے۔
مانع حمل ادویات کے استعمال اور اس کے سنگین سائیڈ ایفیکٹس کے درمیان ربط کو ثابت کرنے میں دس برس لگ گئے۔
1970 میں امریکہ کی حکومتی سطح پر ہونے والی انکوائری کے بعد اس گولی کے ہارمونز کی سطح ڈرامائی طور پر کم کر دی گئی۔
اس کے نتیجے میں ایک اور چیز بھی ہوئی کہ اب کسی بھی خریدار کو ہر پیکٹ کے اندر ایک معلوماتی پرچہ ملتا جس پر اس کا مکمل نسخہ درج ہوتا۔
اس گولی نے عالمی سطح پر بڑھتی ہوئی آبادی کے خلاف انتہائی موثر کردار ادا کیا جس کے بعد خاندان مختصر اور معاشی طور پر زیادہ مستحکم ہوئے کیونکہ خواتین کے لیے ملازمتیں کرنا آسان ہو گیا اور ایک نئی افرادی قوت میسر آئی۔
تاہم آج بھی یہ سوالات اپنی جگہ موجود اور جواب طلب ہیں کہ کس طرح طب کے پیشے نے خاص طور پر پورٹو ریکو میں کمزور طبقے کی خواتین کے جسموں پر پیشگی اجازت اور ممکنہ ضمنی مضر اثرات سے آگاہ کیے بغیر تجربات کیے۔
5 ڈائزیپام
اعصابی نظام کو پرسکون کرنے والی ادویات کی ایک قسم بینزو ڈائزاپین (benzodiazepine) پہلی مرتبہ 1955 میں تیار کی گئی تھی اور دوا ساز کمپنی ہاف مین لا روش نے اسے ’لبریم‘ (Librium) کے طور پر مارکیٹ میں متعارف کروایا تھا۔
یہ اور اس قسم کی باقی ادوایات بے چینی کے ’علاج‘ کے طور پر فروخت نہیں کی گئی تھیں۔ بلکہ ان کا استعمال سائیکو تھراپی میں مشغول رکھنے کے لیے کیا گیا تھا یعنی سائیکو تھراپی حقیقی حل تصور کی گئی تھی اور یہ اسے تکمیل تک پہنچانے میں محض معاون تھی۔
پولش امریکن کیمیا دان لیو سٹرن باخ اور ان کے ریسرچ گروپ نے 1959 میں لبریم کو کیمیائی طور پر تبدیل کیا اور ایک زیادہ طاقت ور دوا کے روپ میں بدل ڈالا۔ اس طرح ڈائزیپام وجود میں آئی جس کی تشہیر 1963 سے ’ویلیم‘ کے برینڈ نام سے فروخت کی جانے لگی۔
اس طرح کی آسانی سے دستیاب ہونے والی اور کم قیمت ادویات نے گہرے اثرات مرتب کیے۔ 1969 سے لے کر 1982 تک امریکہ میں سب سے زیادہ فروخت ہونے والی دوا ویلیز ہی تھی۔
ان ادوایات نے ایک پورے نئے کلچر کی بنیاد رکھی۔ اب لوگ ادویات کے ذریعے تناؤ اور اضطراب پر قابو پانے لگے۔
ویلیم نے اعصابی نظام کو پرسکون کر کے اضطراب اور تناؤ سے نجات دلانے والی جدید ادویات کا راستہ ہموار کیا۔
ان نئی ادویات کی بھاری مقدار لینا زیادہ مشکل (مگر ناممکن نہیں) تھا اور ان کے ضمنی مضر اثرات کم تھے۔ فلوکسیٹین (Fluoxetine) پہلی Selective serotonin reuptake inhibitor تھی جسے 1987 میں ’پروزیک‘ Prozac کے نام سے مارکیٹ میں پیش کیا گیا۔
نوٹ: یہ تحریر پہلے ’دا کنورسیشن‘ پر شائع ہوئی تھی اور یہاں اس کا ترجمہ اجازت سے پیش کیا جا رہا ہے۔ اس کی مصنفہ فلیپا مارٹائر یونیورسٹی آف ویسٹرن آسٹریلیا میں فارماکالوجی کی لیکچرر ہیں۔